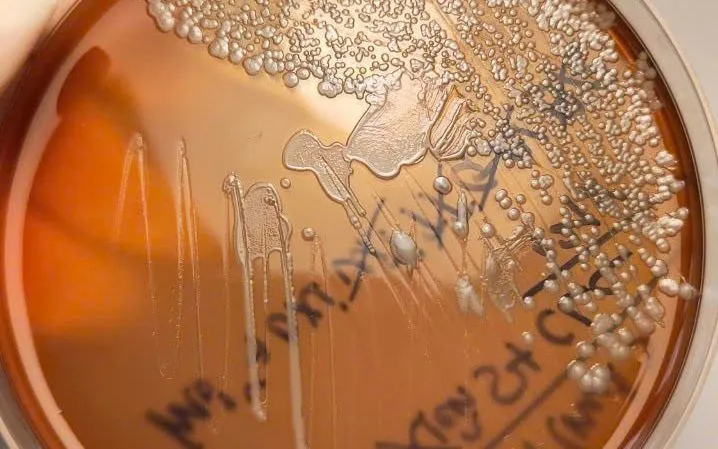

Bệnh nhân là L.H.T., nam, sinh năm 1959, trú tại xã Ea Rốk.
Theo thông tin dịch tễ, ngày 8/1, bệnh nhân đến chơi tại nhà người thân ở xã Krông Năng, sau đó xuất hiện triệu chứng đau, tê bì chân phải và bí tiểu. Ngày 9/1, bệnh nhân đi khám tại phòng khám tư và dùng thuốc nhưng không cải thiện nên nhập viện điều trị.
Đến ngày 15/1, bệnh nhân được đưa vào Bệnh viện Đại học Y Dược Buôn Ma Thuột trong tình trạng nhiễm khuẩn nặng với nhiều bệnh lý kèm theo như nghi áp xe tuyến tiền liệt, viêm thận, viêm mô bào cổ chân phải, tăng huyết áp, đái tháo đường type II và theo dõi huyết khối tĩnh mạch chi dưới.
Ngày 20/1, kết quả xét nghiệm xác định bệnh nhân dương tính với vi khuẩn Burkholderia pseudomallei, qua đó chẩn đoán mắc bệnh Whitmore.
Ngay sau khi phát hiện ca bệnh, Trung tâm Kiểm soát bệnh tật địa phương đã triển khai truyền thông trực tiếp tại gia đình bệnh nhân và các hộ dân xung quanh về nguy cơ và biện pháp phòng, chống bệnh Whitmore. Trạm Y tế địa phương được yêu cầu tăng cường giám sát sức khỏe người dân trong khu vực, lập danh sách theo dõi các trường hợp có biểu hiện nghi ngờ như sốt, viêm phổi, áp xe để báo cáo kịp thời, xử lý sớm.
Ngành Y tế khuyến cáo người dân khi lao động, đặc biệt trong môi trường đất, nước bẩn, cần sử dụng đồ bảo hộ như găng tay, ủng; xử lý và che chắn kỹ các vết thương hở; sử dụng nguồn nước hợp vệ sinh nhằm giảm nguy cơ mắc bệnh Whitmore - một bệnh truyền nhiễm nguy hiểm nhưng có thể phòng tránh nếu thực hiện tốt các biện pháp bảo hộ cá nhân.












